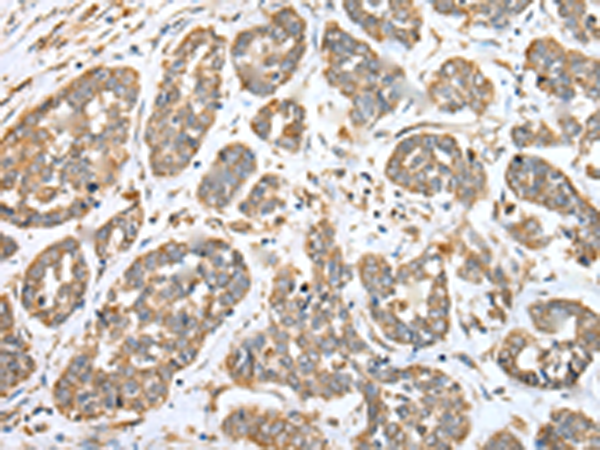

中文名稱:兔抗ATP6V1E2多克隆抗體
|
Background: |
Subunit of the peripheral V1 complex of vacuolar ATPase essential for assembly or catalytic function. V-ATPase is responsible for acidifying a variety of intracellular compartments in eukaryotic cells. This isoform is essential for energy coupling involved in acidification of acrosome. |
|
Applications: |
ELISA, WB, IHC |
|
Name of antibody: |
ATP6V1E2 |
|
Immunogen: |
Full length fusion protein |
|
Full name: |
ATPase, H+ transporting, lysosomal 31kDa, V1 subunit E2 |
|
Synonyms: |
VMA4; ATP6E1; ATP6EL2; ATP6V1EL2 |
|
SwissProt: |
Q96A05 |
|
ELISA Recommended dilution: |
5000-10000 |
|
IHC positive control: |
Human esophagus cancer |
|
IHC Recommend dilution: |
25-100 |
|
WB Predicted band size: |
26 kDa |
|
WB Positive control: |
Mouse brain tissue and TM4 cell |
|
WB Recommended dilution: |
200-1000 |

購物車
幫助
021-54845833/15800441009
